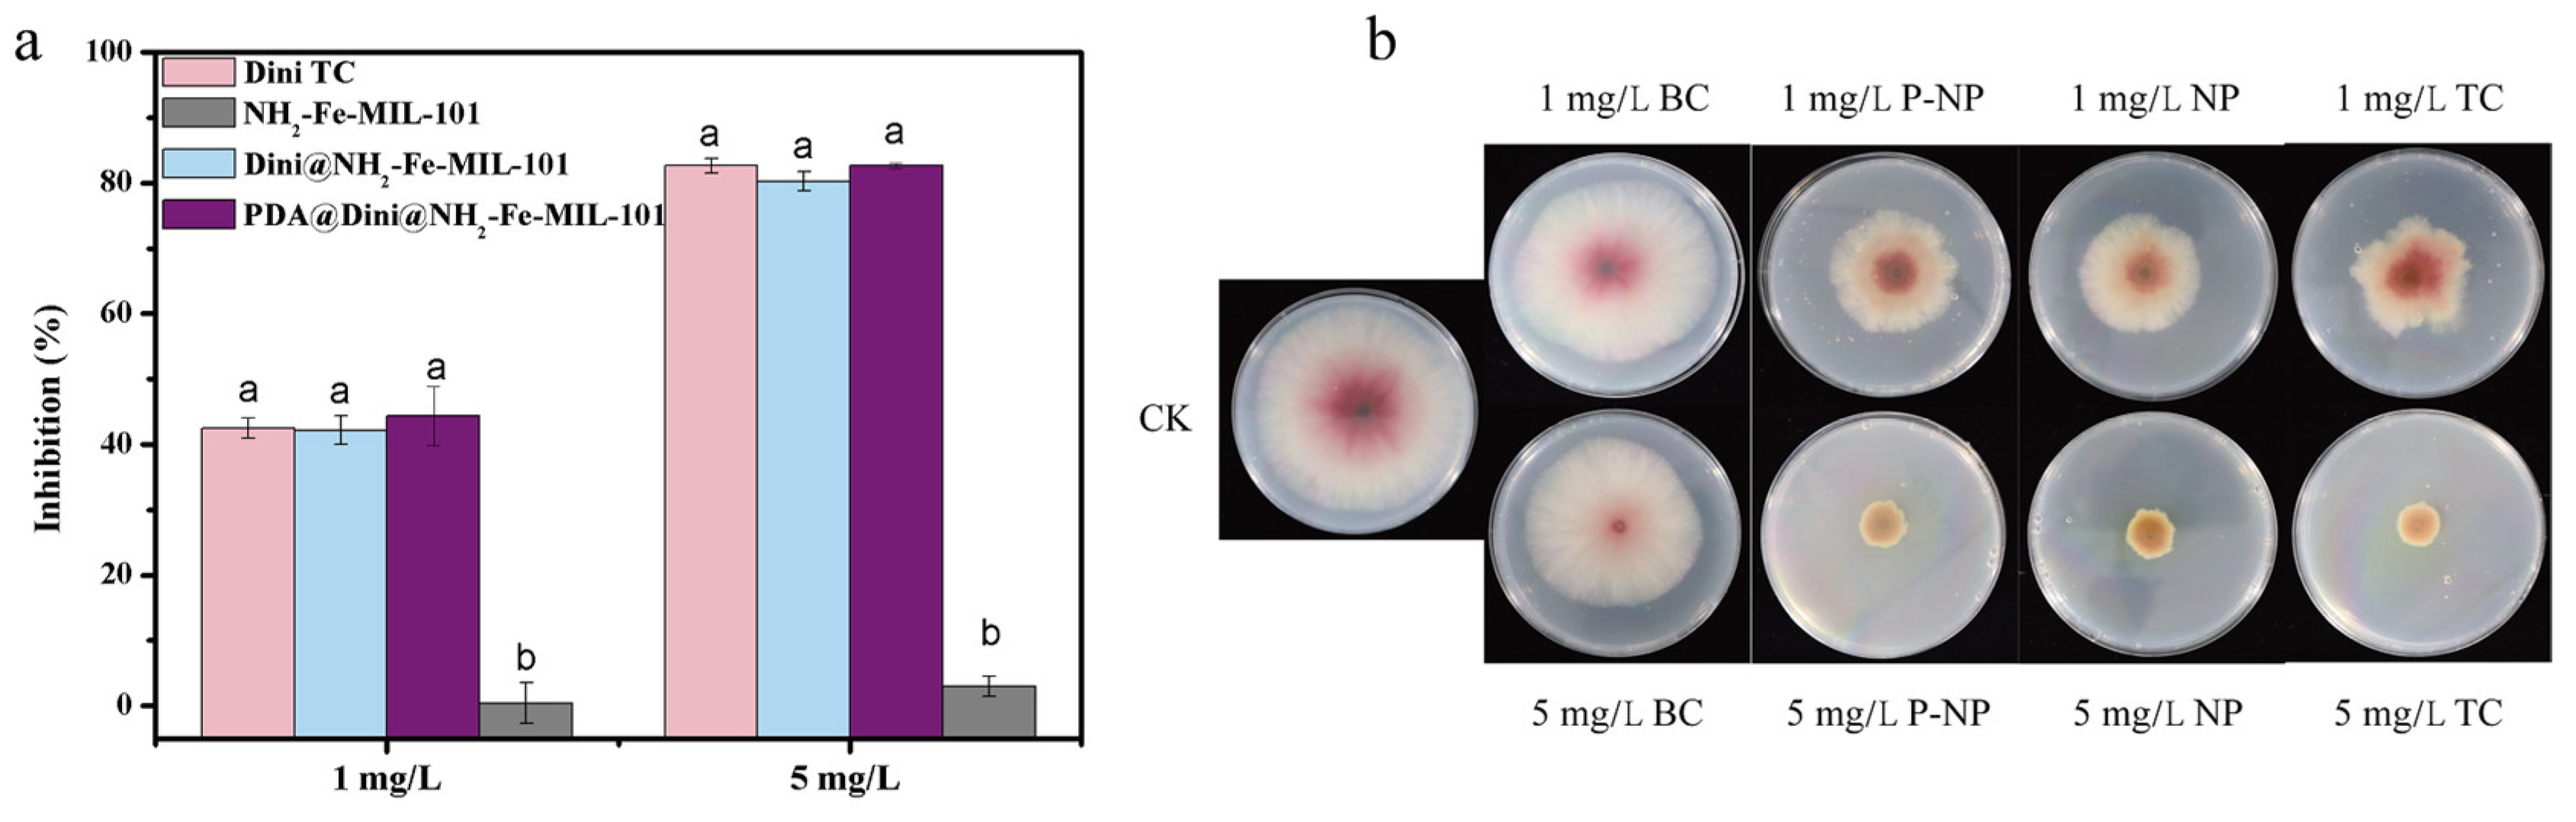
Nanomaterials 10 02000 g008

Polydopamine-Modified Metal–Organic Frameworks, NH2-Fe-MIL-101, as pH-Sensitive Nanocarriers for Controlled Pesticide Release
Abstract
:1. Introduction
2. Materials and Methods
2.1. Materials
2.2. Synthesis of the Nanoparticles
2.2.1. Synthesis of NH2-Fe-MIL-101 Nanocrystals
2.2.2. Preparation of Dini@NH2-Fe-MIL-101 Nanocrystals
2.2.3. Preparation of Dopamine-Coated Dini@NH2-Fe-MIL-101 Nanocrystals
2.3. Sample Characterization
2.4. In Vitro Release of Dini
2.5. Bioactivity Studies
2.6. Statistical Analysis
3. Results and Discussion
3.1. Preparation and Characterization of Nanoparticles
3.2. Loading of Dini into NH2-Fe-MIL-101 Nanoparticles
3.3. pH-Sensitive Release
3.4. Bioassay of Dini-Loaded Nanoparticles
4. Conclusions
Author Contributions
Funding
Conflicts of Interest
References
- Begum, S.; Hassan, Z.; Bräse, S.; Wöll, C.; Tsotsalas, M. Metal–organic framework-templated biomaterials: Recent progress in synthesis, functionalization, and applications. Acc. Chem. Res. 2019, 52, 1598–1610. [Google Scholar] [CrossRef]
- Jiao, L.; Seow, J.; Skinner, W.; Wang, Z.; Jiang, H.-L. Metal–organic frameworks: Structures and functional applications. Mater. Today 2018, 27, 43–68. [Google Scholar] [CrossRef]
- Li, H.; Wang, K.; Sun, Y.; Lollar, C.T.; Li, J.; Zhou, H. Recent advances in gas storage and separation using metal–organic frameworks. Mater. Today 2018, 21, 108–121. [Google Scholar] [CrossRef]
- Lin, R.-B.; Xiang, S.; Zhou, W.; Chen, B. Microporous metal–organic framework materials for gas separation. Chem 2020, 6, 337–363. [Google Scholar] [CrossRef]
- Pal, T.K.; De, D.; Bharadwaj, P.K. Metal–organic frameworks for the chemical fixation of CO2 into cyclic carbonates. Coordin. Chem. Rev. 2020, 408, 213173. [Google Scholar] [CrossRef]
- Qiu, T.; Liang, Z.; Guo, W.; Tabassum, H.; Gao, S.; Zou, R. Metal–organic framework-based materials for energy conversion and storage. ACS Energy Lett. 2020, 5, 520–532. [Google Scholar] [CrossRef] [Green Version]
- Kim, H.; Yang, S.; Rao, S.R.; Narayanan, S.; Kapustin, E.A.; Furukawa, H.; Yaghi, E.N.; Wang, E.N. Water harvesting from air with metal–organic frameworks powered by natural sunlight. Science 2017, 356, 430–434. [Google Scholar] [CrossRef] [Green Version]
- Luo, H.; Zeng, Z.; Zeng, G.; Zhang, C.; Xiao, R.; Huang, D.; Lai, C.; Cheng, M.; Wang, W.; Xiong, W.; et al. Recent progress on metal–organic frameworks based- and derived photocatalysts for water splitting. Chem. Eng. J. 2020, 383, 123196. [Google Scholar] [CrossRef]
- Zhu, L.; Liu, X.-Q.; Jiang, H.-L.; Sun, L.-B. Metal–organic frameworks for heterogeneous basic catalysis. Chem. Rev. 2017, 117, 8129–8176. [Google Scholar] [CrossRef]
- Ma, D.; Li, B.; Shi, Z. Multi-functional sites catalysts based on post-synthetic modification of metal–organic frameworks. Chin. Chem. Lett. 2018, 29, 827–830. [Google Scholar] [CrossRef]
- Kreno, L.E.; Leong, K.; Farha, O.K.; Allendorf, M.; Van Duyne, R.P.; Hupp, J.T. Metal–organic framework materials as chemical sensors. Chem. Rev. 2012, 112, 1105–1125. [Google Scholar] [CrossRef] [PubMed]
- He, J.; Xu, J.; Yin, J.; Li, N.; Bu, X.-H. Recent advances in luminescent metal–organic frameworks for chemical sensors. Sci. China Mater. 2019, 62, 1655–1678. [Google Scholar] [CrossRef] [Green Version]
- Gao, Y.; Liu, G.; Gao, M.; Huang, X.; Xu, D. Recent advances and applications of magnetic metal–organic frameworks in adsorption and enrichment removal of food and environmental pollutants. Crit. Rev. Anal. Chem. 2019. [Google Scholar] [CrossRef] [PubMed]
- Zhu, L.; Meng, L.; Shi, J.; Li, J.; Zhang, X.; Feng, M. Metal–organic frameworks/carbon-based materials for environmental remediation: A state-of-the-art mini-review. J. Environ. Manag. 2019, 232, 964–977. [Google Scholar] [CrossRef]
- Song, Y.; Wang, L.; Xie, Z. Metal–organic frameworks for photodynamic therapy: Emerging synergistic cancer therapy. Biotechnol. J. 2020. [Google Scholar] [CrossRef]
- Wang, Y.; Yan, J.; Wen, N.; Xiong, H.; Cai, S.; He, Q.; Hu, Y.; Peng, D.; Liu, Z.; Liu, Y. Metal–organic frameworks for stimuli-responsive drug delivery. Biomaterials 2020, 230, 119619. [Google Scholar] [CrossRef]
- Xu, C.; Cao, L.; Zhao, P.; Zhou, Z.; Cao, C.; Li, F.; Huang, Q. Emulsion-based synchronous pesticide encapsulation and surface modification of mesoporous silica nanoparticles with carboxymethyl chitosan for controlled azoxystrobin release. Chem. Eng. J. 2018, 348, 244–254. [Google Scholar] [CrossRef]
- Mattos, B.D.; Tardy, B.L.; Magalhães, W.L.E.; Rojas, O.J. Controlled release for crop and wood protection: Recent progress toward sustainable and safe nanostructured biocidal systems. J. Control. Release 2017, 262, 139–150. [Google Scholar] [CrossRef]
- Singh, A.; Dhiman, N.; Kar, A.K.; Singh, D.; Purohit, M.P.; Ghosh, D.; Patnaik, S. Advances in controlled release pesticide formulations: Prospects to safer integrated pest management and sustainable agriculture. J. Hazard. Mater. 2020, 385, 121525. [Google Scholar] [CrossRef]
- Yusoff, S.N.M.; Kamari, A.; Aljafree, N.F.A. A review of materials used as carrier agents in pesticide formulations. Int. J. Environ. Sci. Technol. 2016, 13, 1–18. [Google Scholar] [CrossRef]
- Khandelwal, N.; Barbole, R.S.; Banerjee, S.S.; Chate, G.P.; Biradar, A.V.; Khandare, J.J.; Giri, A.P. Budding trends in integrated pest management using advanced micro-and nano-materials: Challenges and perspectives. J. Environ. Manag. 2016, 184, 157–169. [Google Scholar] [CrossRef] [PubMed]
- Yang, J.; Trickett, C.A.; Alahmadi, S.B.; Alshammari, A.S.; Yaghi, O.M. Calcium L-lactate frameworks as naturally degradable carriers for pesticides. J. Am. Chem. Soc. 2017, 139, 8118–8121. [Google Scholar] [CrossRef] [PubMed]
- Kazan, K. Diverse roles of jasmonates and ethylene in abiotic stress tolerance. Trends Plant Sci. 2015, 20, 219–229. [Google Scholar] [CrossRef] [PubMed]
- Guan, Y.; Teng, Z.; Mei, L.; Zhang, J.; Wang, Q.; Luo, Y. An entrapped metal–organic framework system for controlled release of ethylene. J. Colloid Interface Sci. 2019, 533, 207–215. [Google Scholar] [CrossRef] [PubMed]
- Tang, J.; Ding, G.; Niu, J.; Zhang, W.; Tang, G.; Liang, Y.; Fan, C.; Dong, H.; Yang, J.; Li, J.; et al. Preparation and characterization of tebuconazole metal–organic framework-based microcapsules with dual-microbicidal activity. Chem. Eng. J. 2019, 359, 225–232. [Google Scholar] [CrossRef]
- Xia, Q.; Wang, H.; Huang, B.; Yuan, X.; Zhang, J.; Zhang, J.; Jiang, L.; Xiong, T.; Zeng, G. State-of-the-art advances and challenges of iron-based metal organic frameworks from attractive features, synthesis to multifunctional applications. Small 2019, 15, 1803088. [Google Scholar] [CrossRef]
- Liu, X.; Zhou, Y.; Zhang, J.; Tang, L.; Luo, L.; Zeng, G. Iron containing metal–organic frameworks: Structure, synthesis, and applications in environmental remediation. ACS Appl. Mater. Interfaces 2017, 9, 20255–20275. [Google Scholar] [CrossRef]
- Caliskan, S.; Ozkaya, I.; Caliskan, M.E.; Arslan, M. The effects of nitrogen and iron fertilization on growth, yield and fertilizer use efficiency of soybean in a Mediterranean-type soil. Field Crop. Res. 2008, 108, 126–132. [Google Scholar] [CrossRef]
- Shan, Y.; Cao, L.; Bilal, M.; Xu, B.; Zhao, P.; Cao, C.; Huang, Q. Iron-based porous metal–organic frameworks with crop nutritional function as carriers for controlled fungicide release. J. Colloid Interf. Sci. 2020, 566, 383–393. [Google Scholar] [CrossRef]
- Lee, H.; Dellatore, S.M.; Miller, W.M.; Messersmith, P.B. Mussel-inspired surface chemistry for multifunctional coatings. Science 2007, 318, 426–430. [Google Scholar] [CrossRef] [Green Version]
- Ryu, J.H.; Messersmith, P.B.; Lee, H. Polydopamine surface chemistry: A decade of discovery. ACS Appl. Mater. Interfaces 2018, 10, 7523–7540. [Google Scholar] [CrossRef] [PubMed]
- Cheng, W.; Zeng, X.; Chen, H.; Li, Z.; Zeng, W.; Mei, L.; Zhao, Y. Versatile polydopamine platforms: Synthesis and promising applications for surface modification and advanced nanomedicine. ACS Nano 2019, 13, 8537–8565. [Google Scholar] [CrossRef] [PubMed]
- Xu, P.; Liao, G. A novel fluorescent biosensor for adenosine triphosphate detection based on a metal–organic framework coating polydopamine layer. Materials 2018, 11, 1616. [Google Scholar] [CrossRef] [PubMed] [Green Version]
- Lv, F.; Gan, N.; Huang, J.; Dong, Y.; Zhang, L.; Jiang, S. A poly-dopamine based metal–organic framework coating of the type PDA-MIL-53(Fe) for ultrasound-assisted solid-phase microextraction of polychlorinated biphenyls prior to their determination by GC-MS. Microchim. Acta 2017, 184, 2561–2568. [Google Scholar] [CrossRef]
- Sun, D.T.; Peng, L.; Reeder, W.S.; Moosavi, S.M.; Tiana, D.; Britt, D.K.; Oveisi, E.; Queen, W.L. Rapid, selective heavy metal removal from water by a metal–organic framework/polydopamine composite. ACS Cent. Sci. 2018, 4, 349–356. [Google Scholar] [CrossRef] [PubMed] [Green Version]
- Yu, B.; Ye, G.; Zeng, Z.; Zhang, L.; Chen, J.; Ma, S. Mussel-inspired polydopamine chemistry to modulate template synthesis of 1D metal–organic framework superstructures. J. Mater. Chem. A 2018, 6, 21567–21576. [Google Scholar] [CrossRef]
- Wu, W.; Li, Z.; Chen, Y.; Li, W. Polydopamine-modified metal–organic framework membrane with enhanced selectivity for carbon capture. Environ. Sci. Technol. 2019, 53, 3764–3772. [Google Scholar] [CrossRef]
- Ye, Z.; Wu, S.; Zheng, C.; Yang, L.; Zhang, P.; Zhang, Z. Self-etching of metal–organic framework templates during polydopamine coating: Nonspherical polydopamine capsules and potential intracellular trafficking of metal ions. Langmuir 2017, 33, 12952–12959. [Google Scholar] [CrossRef]
- Wang, D.; Wu, H.; Zhou, J.; Xu, P.; Wang, C.; Shi, R.; Wang, H.; Wang, H.; Guo, Z.; Chen, Q. In situ one-pot synthesis of MOF—Polydopamine hybrid nanogels with enhanced photothermal effect for targeted cancer therapy. Adv. Sci. 2018, 5, 1800287. [Google Scholar] [CrossRef]
- Li, S.; Zhang, L.; Liang, X.; Wang, T.; Chen, X.; Liu, C.; Li, L.; Wang, C. Tailored synthesis of hollow MOF/polydopamine Janus nanoparticles for synergistic multi-drug chemo-photothermal therapy. Chem. Eng. J. 2019, 378, 122175. [Google Scholar] [CrossRef]
- Zheng, Q.; Lin, T.; Wu, H.; Guo, L.; Ye, P.; Hao, Y.; Guo, Q.; Jiang, J.; Fu, F.; Chen, G. Mussel-inspired polydopamine coated mesoporous silica nanoparticles as pH-sensitive nanocarriers for controlled release. Int. J. Pharmaceut. 2014, 463, 22–26. [Google Scholar] [CrossRef] [PubMed]
- Li, X.; Xie, C.; Xia, H.; Wang, Z. pH and ultrasound dual-responsive polydopamine-coated mesoporous silica nanoparticles for controlled drug delivery. Langmuir 2018, 34, 9974–9981. [Google Scholar] [CrossRef] [PubMed]
- Lei, W.; Sun, C.; Jiang, T.; Gao, Y.; Yang, Y.; Zhao, Q.; Wang, S. Polydopamine-coated mesoporous silica nanoparticles for multi-responsive drug delivery and combined chemo-photothermal therapy. Mat. Sci. Eng. C 2019, 105, 110103. [Google Scholar] [CrossRef] [PubMed]
- Chen, J.H.; Wang, H.L.; Guo, B.Y.; Xu, P.; Li, J.Z. The enantioselective pharmacokinetics metabolism of diniconazole in quail (Coturnix coturnixs japonica). Chirality 2013, 25, 910–916. [Google Scholar] [CrossRef]
- Horcajada, P.; Chalati, T.; Serre, C.; Gillet, B.; Sebrie, C.; Baati, T.; Eubank, J.F.; Heurtaux, D.; Clayette, P.; Kreuz, C.; et al. Porous metal–organic-framework nanoscale carriers as a potential platform for drug delivery and imaging. Nat. Mater. 2009, 9, 172–178. [Google Scholar] [CrossRef]
- Xie, Y.; Yan, B.; Xu, H.; Chen, J.; Liu, Q.; Deng, Y.; Zeng, H. Highly regenerable mussel-inspired Fe3O4@polydopamine-Ag core-shell microspheres as catalyst and adsorbent for methylene blue removal. ACS Appl. Mater. Inter. 2014, 6, 8845–8852. [Google Scholar] [CrossRef]
- Bauer, S.; Serre, C.; Devic, T.; Horcajada, P.; Marrot, J.; Ferey, G.; Stock, N. High-throughput assisted rationalization of the formation of metal organic frameworks in the iron (III) aminoterephthalate solvothermal system. Inorg. Chem. 2008, 47, 7568–7576. [Google Scholar] [CrossRef]
- Dong, Y.; Hu, T.; Pudukudy, M.; Su, H.; Jiang, L.; Shan, S.; Jia, Q. Influence of microwave-assisted synthesis on the structural and textural properties of mesoporous MIL-101(Fe) and NH2-MIL-101(Fe) for enhanced tetracycline adsorption. Mater. Chem. Phys. 2020, 251, 123060. [Google Scholar] [CrossRef]
- Wang, D.; Li, Z. Bi-functional NH2-MIL-101(Fe) for one-pot tandem photo-oxidation/Knoevenagel condensation between aromatic alcohols and active methylene compounds. Catal. Sci. Technol. 2015, 5, 1623–1628. [Google Scholar] [CrossRef]
- Boontongto, T.; Burakham, R. Evaluation of metal–organic framework NH2-MIL-101(Fe) as an efficient sorbent for dispersive micro-solid phase extraction of phenolic pollutants in environmental water samples. Heliyon 2019, 5, e02848. [Google Scholar] [CrossRef]
- Zou, A.; Yang, Y.; Cheng, J.; Garamus, V.M.; Li, N. Construction and characterization of a novel sustained-release delivery system for hydrophobic pesticides using biodegradable polydopamine-based microcapsules. J. Agric. Food Chem. 2018, 66, 6262–6268. [Google Scholar] [CrossRef] [PubMed]
- Wen, H.; Zhou, H.; Hao, L.; Chen, H.; Xu, H.; Zhou, X. Enzyme cum pH dual-responsive controlled release of avermectin from functional polydopamine microcapsules. Colloids Surf. B 2020, 186, 110699. [Google Scholar] [CrossRef] [PubMed]

| Sample | SBET (m2/g) | Vt (cm3/g) | DBJH (nm) |
|---|---|---|---|
| NH2-Fe-MIL-101 | 953.9 | 0.77 | 3.2 |
| Dini@NH2-Fe-MIL-101 | 449.8 | 0.34 | 3.0 |
| PDA@Dini@NH2-Fe-MIL-101 | 13.0 | 0.05 | - |
| Entry | Solvent | Mass Ratio | LC (%) | EE (%) |
|---|---|---|---|---|
| 1 | acetone | 1 | 24.9 ± 0.5 | 33.6 ± 2.1 |
| 2 | methanol | 1 | 24.3 ± 0.1 | 32.3 ± 1.1 |
| 3 | dichloromethane | 1 | 28.1 ± 0.1 | 40.8 ± 0.4 |
| 4 | dichloromethane | 0.5 | 23.3 ± 0.2 | 60.9 ± 1.7 |
| 5 | dichloromethane | 2 | 30.9 ± 0.1 | 23.1 ± 0.5 |
| 6 | dichloromethane | 3 | 35.8 ± 0.2 | 19.5 ± 0.2 |
| 7 | dichloromethane | 4 | 43.0 ± 0.2 | 19.3 ± 0.3 |
© 2020 by the authors. Licensee MDPI, Basel, Switzerland. This article is an open access article distributed under the terms and conditions of the Creative Commons Attribution (CC BY) license (http://creativecommons.org/licenses/by/4.0/).
Share and Cite
Shan, Y.; Xu, C.; Zhang, H.; Chen, H.; Bilal, M.; Niu, S.; Cao, L.; Huang, Q. Polydopamine-Modified Metal–Organic Frameworks, NH2-Fe-MIL-101, as pH-Sensitive Nanocarriers for Controlled Pesticide Release. Nanomaterials 2020, 10, 2000. https://doi.org/10.3390/nano10102000
Shan Y, Xu C, Zhang H, Chen H, Bilal M, Niu S, Cao L, Huang Q. Polydopamine-Modified Metal–Organic Frameworks, NH2-Fe-MIL-101, as pH-Sensitive Nanocarriers for Controlled Pesticide Release. Nanomaterials. 2020; 10(10):2000. https://doi.org/10.3390/nano10102000
Chicago/Turabian StyleShan, Yongpan, Chunli Xu, Hongjun Zhang, Huiping Chen, Muhammad Bilal, Shujun Niu, Lidong Cao, and Qiliang Huang. 2020. "Polydopamine-Modified Metal–Organic Frameworks, NH2-Fe-MIL-101, as pH-Sensitive Nanocarriers for Controlled Pesticide Release" Nanomaterials 10, no. 10: 2000. https://doi.org/10.3390/nano10102000
APA StyleShan, Y., Xu, C., Zhang, H., Chen, H., Bilal, M., Niu, S., Cao, L., & Huang, Q. (2020). Polydopamine-Modified Metal–Organic Frameworks, NH2-Fe-MIL-101, as pH-Sensitive Nanocarriers for Controlled Pesticide Release. Nanomaterials, 10(10), 2000. https://doi.org/10.3390/nano10102000






